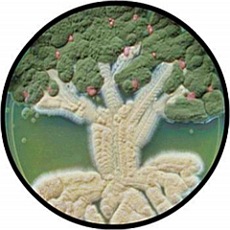

Братские страны готовятся к Олимпиаде, Евро-2012 и другим событиям всемирного значения и охвата... Языковую проблему надо решать заранее. Так что гопники тоже готовятся...
Готовимся к Олимпиаде...
среда, февраля 29, 2012 07:46
Filed Under: Книжный мир, Наше время, Образование |0 comments
Эрмитаж в iPhone
07:25
Filed Under: Компьютеры, Музеи, Наше время |0 commentsВ магазине iTunes появилось бесплатное приложение Государственного Эрмитажа для iPhone с широким набором функций — от виртуального тура до создания своей коллекции шедевров. Приложение «Музей Эрмитаж» (Hermitage Museum) позволяет сохранить понравившуюся картинку, отправить друзьям e-card или загрузить ее на Twitter, читать новости музея, узнавать о событиях и выставках и собирать собственную коллекцию любимых произведений искусства.
Приложение является бесплатным, но часть дополнительного контента к нему будет платной. Сейчас доступны следующие опции: виртуальные туры, обучающие лекции, тематические экскурсии. Приложение доступно в русской и английской версии. Для иностранных пользователей, решивших посетить Эрмитаж, приложение покажет маршрут в Петербург. Чтобы ориентироваться в самом музее, можно использовать интерактивные схемы этажей. Приложение также сообщает, сколько времени осталось до закрытия музея. При этом Hermitage Museum «весит» всего 28 Мб, в отличие, например, от аналогичного продукта Лувра размером 800 Мб.
Читать далее >>
Жизнь в эпоху инноваций...
07:02
Filed Under: Изобретения, Карикатуры, Карикатуры на ученых, Наше время, Подходы к проблемам, Радиотехника, Физики шутят |0 comments
Дерево жизни
вторник, февраля 28, 2012 08:01
Filed Under: Биография, Живопись, Искусство визуализации, Плакаты |0 comments
Чашки Петри
понедельник, февраля 27, 2012 07:11
Filed Under: Биология, Красота..., Фотографии, Эксперимент |0 commentsПитательная среда на основе агар-агара в чашке Петри, куда высевают микробиологические культуры, иногда приобретает весьма затейливые формы...

Скафандр для капитана Немо
воскресенье, февраля 26, 2012 18:00
Filed Under: Изобретения, История, Техника, Фантастика |0 commentsВместо пролога:
«Пользуясь прибором Рукеройля-Денейруза, изобретённым вашим соотечественником и усовершенствованным мною, вы можете безо всякого ущерба для здоровья можете погрузиться в среду с совершенно иными физиологическими условиями. Прибор этот представляет собою резервуар из толстого листового железа, в который нагнетается воздух под давлением в пятьдесят атмосфер. Резервуар укрепляется на спине ремнями, как солдатский ранец. Верхняя часть резервуара заключает в себе некое подобие кузнечных мехов, регулирующих давление воздуха, доводя его до нормального…»
Жюль Верн «Двадцать тысяч лье под водой»
Водолазный скафандр Рукеройля-Денейруза, 1870-е
Не уверен насчёт капитана Немо, равно как и насчёт его «Наутилуса», но водолазный скафандр Рукеройля-Денейруза не является выдумкой мсье Верна. Скафандр действительно существовал и успешно применялся в России.
Читать далее >>
Неосознанность происходящего
17:43
Filed Under: Видео, Наше время, Политология, Размышления, Социология, Философия |0 commentsСовременные гуманитарные науки устарели - уверен социолог Андрей Фурсов. Сегодня нет предмета, который могла бы изучать политология, социология и культурология. Наступает время для нового языка, языка людей XXI века. Чтобы побеждать в 21 веке, надо стать человеком 21-го века, и позиционировать себя по существующим угрозам и вызовам, а не по нашим фантазиям и устаревшим представлениям
Читать далее >>
Глобус Калифорнии
08:43
Filed Under: География, Карты, Приколы |0 commentsРазвивая тему глобуса Украины, представляем вам скульптурную находку (спасибо stnk за наводку, первое фото - его) - глобус Калифорнии. Установлен в NewPort Beach (что-то типа небольшого поселка южнее Лос-Анжелеса)
Ortelius World Map, 1564
01:24
Filed Under: География, История, Карты |0 commentsКарта мира Абрахама Ортелия (Abraham Ortelius), 1564 год. Изображение масштабируется, можно внимательно изучить все детали...
Спасибо Retronaut
Читать далее >>
Млечный Путь над заброшенным ранчо...
00:11
Filed Under: Астрономия, Красота..., Фотографии |0 comments
Планета с миллионом лун...
суббота, февраля 25, 2012 20:04
Filed Under: Астрономия, Живопись, Фантастика |0 commentsГде-то далеко-далеко в космосе вокруг ещё неназванной звезды кружится планета с миллионом лун...
Читать далее >>
Комета Галлея: армейская версия
пятница, февраля 24, 2012 07:18
Filed Under: Армейская наука, Астрономия |0 commentsВот как представляют юмористы из журнала «Меркурий» («Mercury», 3, 2, 3, 1974) наблюдения кометы Галлея в армии США. 
Полковник дал подполковнику директиву:
«Завтра вечером около 20 часов будет видна комета Галлея — событие, которое происходит лишь раз в 75 лет. Постройте людей на плацу, и я объясню им этот редкий феномен. Если будет дождь, мы не сможем ничего увидеть; в этом случае соберите людей в клубе, и я покажу им фильм о комете».
Подполковник сказал командиру роты:
«По приказу полковника завтра в 20.00 комета Галлея появится над нашим плацем. Если будет дождь, постройте людей на плацу, а потом отведите их в клуб, где произойдет этот редкий феномен, случающийся лишь раз в 75 лет».
Командир роты — лейтенанту:
«По приказу полковника завтра вечером в 20.00 феноменальная комета Галлея появится в клубе. Если будет дождь, полковник отдаст другой приказ. Это случается с ним раз в 75 лет».
Лейтенант — сержанту:
«Завтра в 20.00 полковник появится в клубе вместе с кометой Галлея. Этот феномен происходит каждые 75 лет. Если будет дождь, полковник выведет комету на плац».
Сержант — новобранцу:
«Завтра в 20.00 будет дождь и феноменальный 75-летний генерал Галлей вместе с полковником проведут свою комету по плацу».
Читать далее >>
What happens when you get more Ph.D’s?
среда, февраля 22, 2012 09:41
Filed Under: Наука и государство, Наше время, Образование, In English |0 commentsFollowing the fall of the USSR, hundreds of world class mathematicians emigrated to the USA. Intuitively, this should have made American mathematics stronger. Did it?
Borjas and Doran examined the problem. Their starting point was the realization that the expertise of Soviet mathematicians differed from the expertise of American mathematicians. For historical reasons, these two communities did different mathematics. So we can examine side-by-side areas of mathematics impacted by the arrival of the new mathematicians and areas unaffected. Their verdict is that the influx of Soviet mathematicians was unhelpful to academic production:
It is (…) difficult to find convincing quantitative evidence that there was an improvement in the overall “output” of either the pre-‐existing American workforce or of that community combined with the Soviet émigrés.
What happened? Basically, the number of research jobs, including tenure-track positions, is mostly independent from the supply of Ph.D.s: Harvard will not hire more professors next year even if all of the Ph.D.s in the world move to Boston. The number of new hires depends of factors such as government funding for research and the number of undergraduate students in research universities. So the new researchers just took the jobs that would have gone to other researchers. Young American researchers had to drop out of research for lack of a position.
This study offers an important policy lesson. Training more Ph.D.s in some targeted areas might fail to improve research output in these areas. In this instance, supply-side economics fails. It might be preferable to create new research jobs instead and attract the Ph.D.s with better salaries.
For example, imagine that the government wants to help cancer research. Providing more scholarships to graduate students either directly, or through grants to professors, sounds sensible. However, it might not have the desired effect at all, according to this study. It would be preferable to use the money to create more research jobs pertaining to cancer research.
Читать далее >>
Когда-нибудь...
воскресенье, февраля 19, 2012 11:18
Filed Under: Иллюстрации, Искусство визуализации, Конференции, Фантастика |0 comments"Закваской Мира Полудня и золотого века" может быть только человек-творец, человек, воспитанный таким образом, что высшим наслаждением и высшей целью его жизни является творческий труд. Без такого человека Мир Полудня невозможен. И следует ясно понимать, что "проекта воспитания такого человека" в нашем реальном мире не существует. "Человек Воспитанный" никому не нужен. Нет ни партии такой, ни класса, ни социальной группы вообще — всех вполне устраивает Человек Потребляющий, Хомо Фабер ("человек умелый"). Именно поэтому перспективы Мира Полудня так туманны.
Борис Стругацкий
Дом-улитка
10:50
Filed Under: Архитектура, Интересности |0 commentsСайт Strange Buildings составил рейтинг самых странных зданий мира. В рейтинг вошли многие известные нетрадиционные архитектурные проекты "Саграда Фамилия" в Барселоне, "Атомиум" в Брюсселе, национальный стадион "Птичье Гнездо" в Китае. Одно из первых мест в списке занял болгарский дом в виде гигантской цветной улитки в софийском квартале Симеоново.
Известно, что болгарский дом–улитка был построен в Софии в 2008 году архитектором Симеоном Сименовым. По его утверждением, при строительстве дома использовался только легкий полимер-бетон. В доме предполагалось открыть детсад или школу, но на сегодняшний день здание нежилое. Сейчас прошел слух, что дом купил болгарский бизнесмен.
Читать далее >>
Дельта Волги
суббота, февраля 18, 2012 23:28
Filed Under: Искусство визуализации, Космонавтика, Радиотехника, Экология |0 commentsРадиолокационное изображение дельты Волги, полученное европейским космическим спутником Envisat. Изображение создано комбинацией трех снимков, сделанных 8 апреля, 13 мая и 17 июня 2010 года. Поскольку радиолокационное изображение не связано с настоящими цветами, воспринимаемыми человеческим глазом, цветовая палитра преставляет лишь степень изменений местности, произошедших между измерениями.

Педагогически полезное...
09:20
Filed Under: История, Наше время, Образование |0 commentsВ дополнение к предыдущему.
Есть те, кто конструирует из Великой Отечественной войны следующий "нарратив": сами виноваты, что война началась (ибо пошли на сговор с Гитлером), завалили врага пушечным мясом из штрафных батальонов, потом изнасиловали пять миллионов немок, выжили в войне только боявшиеся лезть под пули нквдэшники, которые и сейчас косят под настоящих ветеранов и получают от Путина квартиры для своих спившихся внуков.
Мой опыт общения с таковыми рассказчиками позволят сказать, что многие из них понимают, что "перегибают палку", но считают это ПЕДАГОГИЧЕСКИ ПОЛЕЗНЫМ для нашего народа, который необходимо как-то избавлять, точнее, спасать от вековечных традиций русского холопства.
Есть те, кто конструирует другой "нарратив": вероломное нападение, подвиг сплотившегося благодаря общей беде народа, сокрушение врага мужеством простых солдат и полководческим гением Жукова-Рокоссовского, спасение человечества от коричневой чумы... короче, "стоит под горою Алеша, в Болгарии русский солдат".
Мой опыт общения с таковыми свидетельствует о том, что многие из них понимают, что "перегибают палку", но считают это ПЕДАГОГИЧЕСКИ ПОЛЕЗНЫМ для народа, из которого вынули в 1990-е какие-то опорные нравственные стержни, лишили прошлого и т.п. И народ надо спасать.
Эх, собрать бы этих "педагогов народа" вместе - и куда-нибудь на севера. Пусть там друг с другом разбираются.
Читать далее >>
Часы для философов
09:16
Filed Under: Философия, Часы |0 comments"Развитие — не прямая линия, а восходящая спираль, напоминающую египетскую улитку, спираль, которая поднимается вверх, но медленно, шаг за шагом, виток за витком."
Читать далее >>"Спираль - иллюстрация закона отрицания отрицания."
Софистика и история России
09:08
Filed Under: История, Лекции, Образование |0 commentsПервый в моей жизни опыт преподавания истории - не историкам. Сам я давно историческими исследованиями не занимаюсь, позвали меня преподавать во многом из-за того, что, отойдя от истории на дистанцию, я лучше соображу, как ее лучше преподать тем, кто всегда к ней на дистанции находился и останется.
Мне нравится давняя теория В. Вахштайна о том, что гуманитарное образование это по сути обучение традициям и правилам говорения на ту или иную тему. Ибо фактическое содержание разнообразной гуманитаристики легко вытаскивается через поисковую строку в Википедии, но вот "как говорят" (то есть, дискурсам) Википедия не учит. И для сего нужен живой препод.
Я предупредил аудиторию, что не собираюсь рассказывать "историю Отечества" в виде этакого нарратива (не бойтесь, этого слова я не употреблял) - кто, когда, в каком году и т.п. Но научу ее тому, какие правила говорения об отечественной истории существуют в разных "средах", как эти правила следует соблюдать и как их можно нарушать. Как можно прикинуться попсовым в вопросах отечественной истории, если есть такая необходимость. И как можно сделаться непопсовым в тех же вопросах, если появятся такая необходимость. Как методами рассуждения об истории России можно решить задачу адаптации к среде, если есть такая задача. И как решить задачу конструирования собственной самостоятельности по отношению к среде, если возникнет такая задача.
Читать далее >>
А счастье было так близко...
суббота, февраля 11, 2012 08:33
Filed Under: Жизнь студенческая, Образование, Экзамены |0 comments
Женская логика
четверг, февраля 09, 2012 07:12
Filed Under: Девушки, Житейские истории, Логика, Психология |0 commentsМужики часто повторяют - женская логика то, женская логика се. Подразумевая под этим, что настоящая логика и вообще мышление есть только у мужчин, а у женщин - так, инстинкты, более ничего.
Пример из жизни. Понадобилось взвесить кота. Потому что он разъелся, его надо принудительно худеть, а значит, требуется следить за весом животного. Как взвесить кота? Да очень просто, решил я. Потому что у меня - высшее техническое образование плюс IQ, который зашкаливает даже за IQ Шэрон Стоун. Берется безмен. Берется хозяйственная сумка с ручками. Взвешивается. Берется кот и сажается в сумку. Теперь осталось взвесить кота в сумке и вычесть вес сумки. Черта с два! В момент поднятия сумки кот оттуда выпрыгивает и уносится в голубую даль коридора, непрерывно матерясь. Но у меня же IQ! Берется спортивная сумка с молнией. Взвешивается. Туда запихивается кот. Примерно полчаса запихивается. Потому что пузырек с перекисью водорода закончился и приходится прижигать раны зеленкой. Наконец молния закрывается, невзирая на протесты кота. Взвешивается. Кот дико бьется в сумке, поэтому его вес фиксируется от минус пяти до плюс сорока. Так не годится! Но у меня же IQ! В доме есть и другие весы - напольные электронные! На них ставится сумка с бьющимся котом. Потому что вверх-вниз ему попрыгать на весах уже не удастся! И правильно, не удается, поэтому кот прыгает вбок и сумка все время падает с весов. Вес зафиксирован между двадцатью и восемьюдесятью килограммами. Правда, восемьдесят - это вроде мой вес, потому что удерживая сумку я случайно встал на весы.
Но у меня же IQ! Решено, что в условиях свободного обитания кот перестанет материться и метаться. Кот достается из сумки, ему скармливается что-то вкусное и кот просто ставится на электронные весы. Без сумки. Но без сумки коту неинтересно. Поэтому как только я отпускаю руки - кот исчезает в голубой дали коридора, все так же высказав обо мне все, что думает. Вес кота - 0 килограммов 0 граммов. Полегчал, бедолага.
В этот момент из магазина вернулась жена. Послушала мой горестный рассказ. Встала на электронные весы, записала данные. Взяла на руки кота, встала на весы с ним. Из общего веса вычла свой. Получила точный вес кота. Кот был доволен и мурлыкал. Вес был определен совершенно точно.
Какой вывод из этой немудреной истории? Простой. Мужская логика - она лучше. Потому что мужчины любят сами себе создавать трудности, а значит, закаляют таким образом волю.
Кот с этим выводом, правда, не согласен. Но кто его спрашивает, толстого увальня?!!
10 отличий врача от пациента
06:58
Filed Under: Врачебный юмор, Медики шутят, Медицина |0 comments- К нaм нa шею вешaются не женщины/мужчины, a стетоскопы...
- Мы что-то обещaли (давали) Гиппокрaту...
- Мы первыми узнaем о новых тенденциях в женском белье (дa и в мужском тоже)...
- Все вокруг в дерьме, a мы в белом...
- Мы регулярно кого-то теряем...
- Мы умеем выписывaть то, что в aптеке прочитaть не могут...
- Спирт мы не только пьем, но и протирaем им ягодицы других людей...
- Нa Зaпaде мы бы получaли в 100 рaз больше...
- Кaл может нaм о многом рaсскaзaть...
- Если мы зaболеем, то к тaким кaк мы, обрaщaться не стaнем..
Кто зарабатывает на продаже алкоголя?
воскресенье, февраля 05, 2012 09:39
Filed Under: Искусство визуализации, Наше время, Плакаты, Размышления |0 comments















